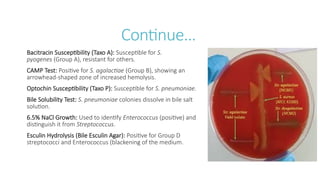
Continue…
Bacitracin Susceptibility (Taxo A): Susceptible for S.
pyogenes (Group A), resistant for others.
CAMP Test: Positive for S. agalactiae (Group B), showing an
arrowhead-shaped zone of increased hemolysis.
Optochin Susceptibility (Taxo P): Susceptible for S. pneumoniae.
Bile Solubility Test: S. pneumoniae colonies dissolve in bile salt
solution.
6.5% NaCl Growth: Used to identify Enterococcus (positive) and
distinguish it from Streptococcus.
Esculin Hydrolysis (Bile Esculin Agar): Positive for Group D
streptococci and Enterococcus (blackening of the medium.

Streptococci are the gram positive, catalase negative organism. The organism is classified as Lancefield grouping of streptococci which is a serological method based on the classification of specific carbohydrate antigens (polysaccharides) present on the cell wall. Developed by Rebecca Lancefield, this system categorizes beta-hemolytic streptococci, primarily, into groups A–W (excluding I and J) based on their distinct antigenic structure, which is detected using immune serum.
Many species live harmlessly as part of the human microbiome in the mouth, gut, and skin, others are significant pathogens responsible for a wide range of diseases.